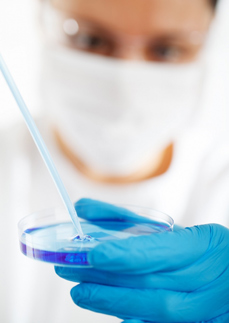

Laboratorní cvičení z mikrobiologie potravin I-a
Authoren
Ing. Zita Bastlová
Annotation
Výukový materiál bude sloužit jako úvod do Laboratorního cvičení z mikrobiologie potravin. Navazuje na získané znalosti a dovednosti v laboratorním cvičení z Obecné mikrobiologie, které bude i nadále prohlubovat. Studenti se seznámí s rozdělením a přípravou živných půd, se základy kultivační techniky, od očkování mikroorganismů až po jejich uchovávání a resuscitaci.
Lizenz
Creative Commons BY-SA 4.0
Sprache
Tschechisch
rok vzniku
2020
cena
ZDARMA
vzniklo za podpory